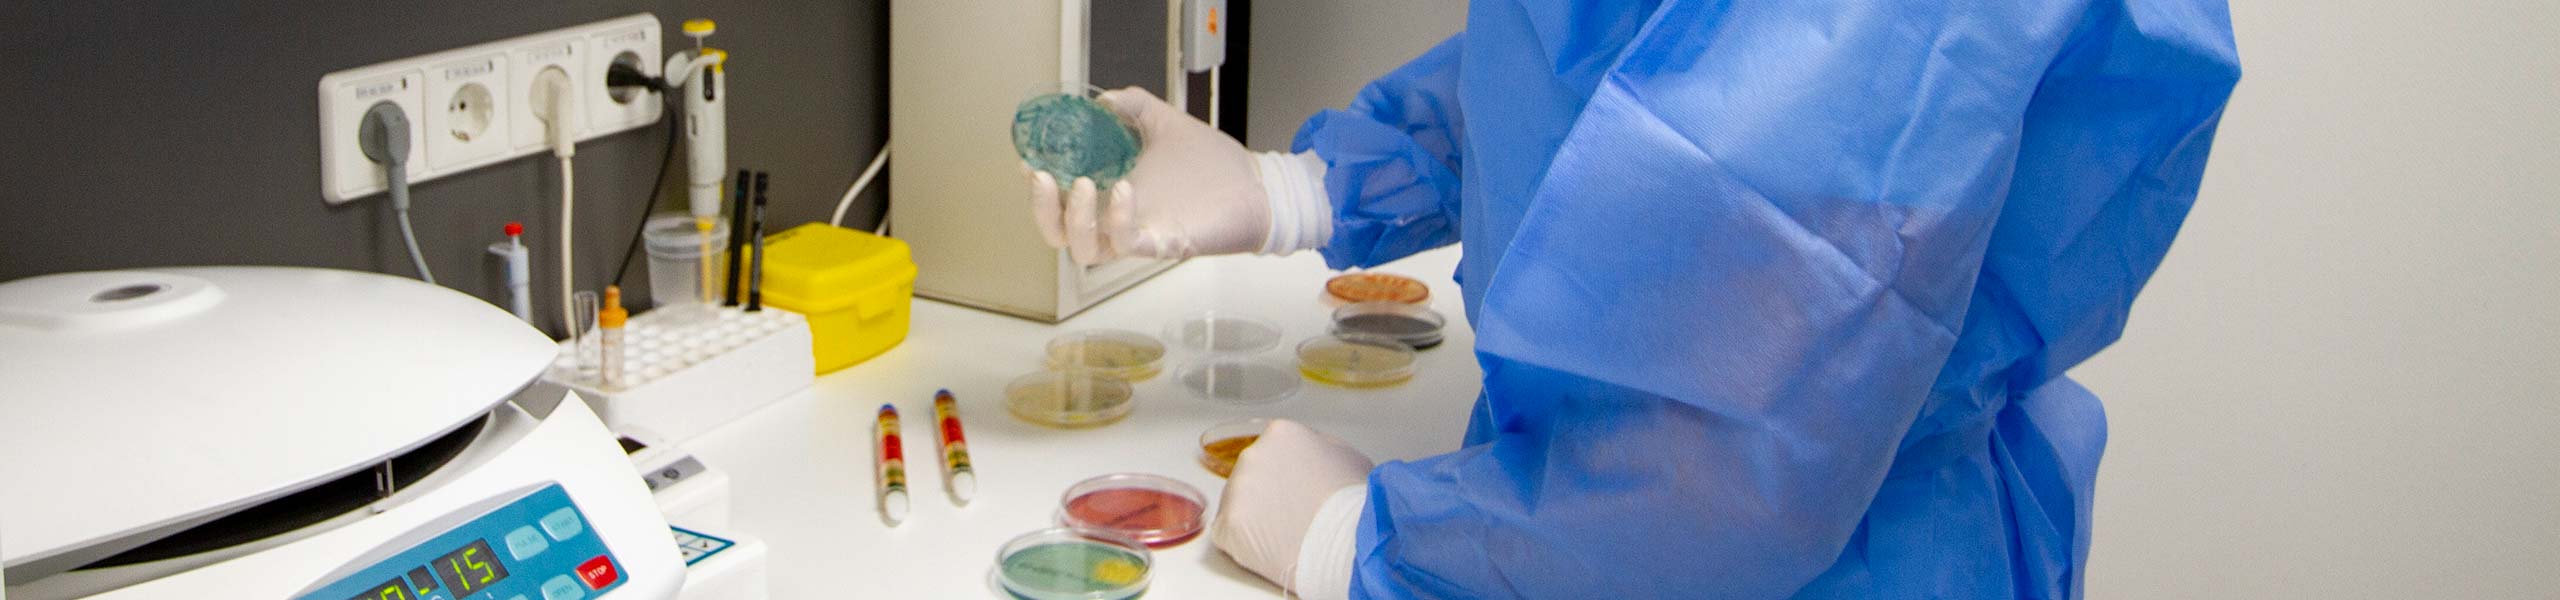

Urologische Praxis Buchen
Dr. med. Peter Breitling
Dr.-Konrad-Adenauer-Str. 37
74722 Buchen (Odenwald)
Telefon: 06281 3313
Fax: 06281 97065
E-Mail: Diese E-Mail-Adresse ist vor Spambots geschützt! Zur Anzeige muss JavaScript eingeschaltet sein!
Verantwortlich für den Inhalt:
Dr. med. Peter Breitling (Adresse wie oben)
Entwurf & Umsetzung
SchreiberGrimm . Werbeagentur GmbH | 74722 Buchen | www.schreibergrimm.com
Rechtliche Hinweise
Die Inhalte unserer Internetseite werden sorgfältig geprüft. Eine Garantie für die Vollständigkeit, Richtigkeit und letzte Aktualität kann jedoch nicht übernommen werden. Wir sind für den Inhalt von Websites, auf die von unseren Seiten verlinkt wird, nicht verantwortlich. Der Verweis mittels Hyperlink stellt auch keine Empfehlung dieser Websites oder der sie betreibenden Unternehmen oder ihrer Produkte durch uns dar.
Haftungsansprüche, die durch die Nutzung unseres Internetangebotes verursacht werden, sind ausgeschlossen, sofern wir nicht vorsätzlich oder grob fahrlässig gehandelt haben. Des weiteren behalten wir uns das Recht vor, Änderungen oder Ergänzungen der bereitgestellten Informationen vorzunehmen.